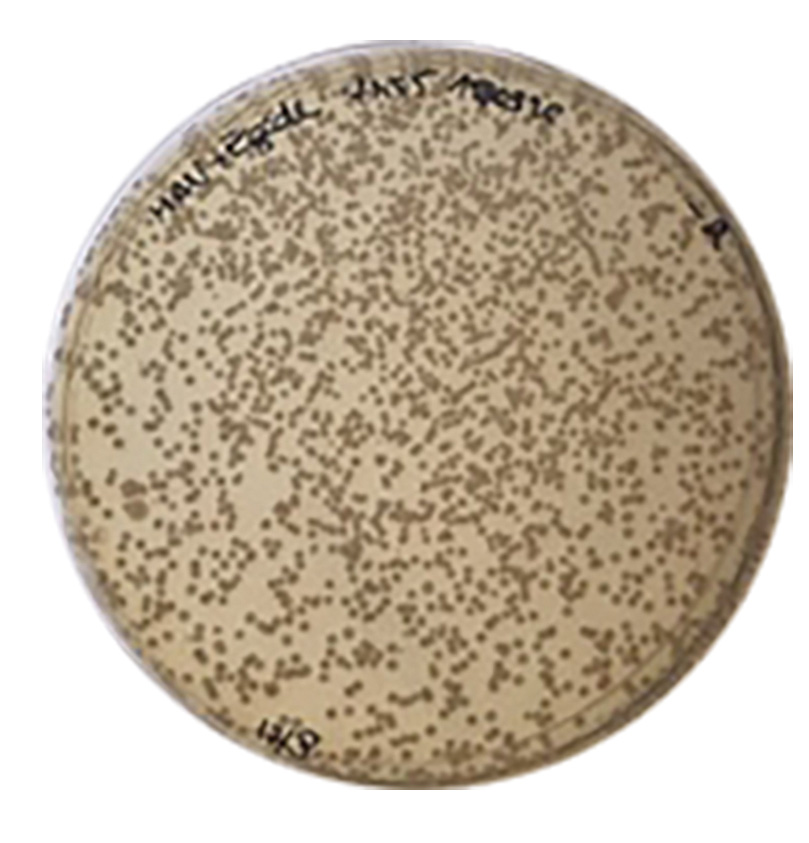

Partant de ce constat,
LAFFORT® a mené des essais portant sur l’effet de
BIOProtection de
ZYMAFLORE® ÉGIDETDMP appliquée par pulvérisation sur matériel de récolte en contact avec le raisin (machine à vendanger, benne de vendange, réception vendange, citerne de transport des moûts, cagette de récolte etc.).
Les résultats de ces essais démontrent que ZYMAFLORE® ÉGIDETDMP limite significativement la présence de micro-organismes potentiellement indésirables en colonisant la surface du matériel et les raisins tout au long de la journée de récolte.
De cette manière ZYMAFLORE® ÉGIDETDMP joue pleinement son rôle de BIOProtection sur les raisins avant encuvage pour préserver la qualité des vins.
Dénombrement de la microflore des raisins sur milieu de culture « levures totales » :
(Pulvérisation préalable d’une solution de ZYMAFLORE® ÉGIDETDMP à 50 g/L sur machine à vendanger et benne de vendange).


Témoin sans
BIOProtection : présence importante
de moisissures et de micro-organismes
potentiellement indésirables sur raisins en fin de
journée de récolte.
BIOProtection avec ZYMAFLORE® ÉGIDETDMP :
colonisation exclusive et progressive des raisins
par ZYMAFLORE® ÉGIDETDMP durant la journée de
récolte et absence de moisissures.
Sachet de 500g
Pour plus d’informations, Consultez notre focus sur notre site internet en cliquant ici !